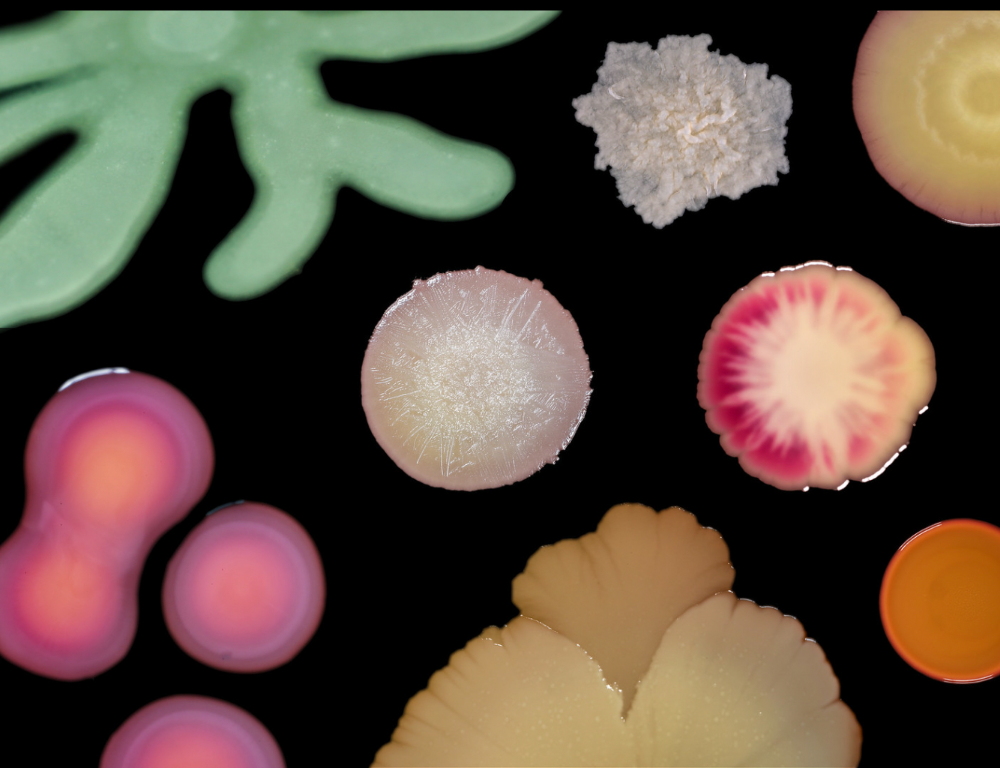
Diverse collection of various microorganisms in vibrant colors and shapes, showcasing nature's beauty.

MICROORGANISMS
A healthy body and clean water are maintained by the diversity and balance of the community of microorganisms within them. In recent years, many researchers have been focusing less on the activity of single-strains of microorganisms and more on aggregates of microorganisms called microbiomes.

RAINFOREST BIOTECHNOLOGY
What is EM?
EM, which treats microorganisms as aggregates, was developed long before microbiome science caught the world’ s attention.
Its effectiveness has been demonstrated for three decades across the globe on fields in agriculture and treating intractable illnesses in medicine.
Moreover, they are the first group of organisms that managed to populate the earth by purifying it of toxic gases and water, preparing a fertile green future.
Microbiome studies have shown that quadrillions of microorganisms live within and on the human body and that these microorganisms make a significant difference to human health.
Many of them live in the human gut and affect not only people’ s physical health, but also their mental condition.

2025 - TODAY
Microbes in Clinical Research
Accordingly, knowledge of microorganisms in conventional research has primarily followed optical-technical developments.
Modern science is severely hampered in dealing with the invisible, which are categorised into 5 different groups: photosynthetic bacteria, lactic acid bacteria, archaea, protists, fungi and yeasts, green algae, actinomycetes and their combinations and compounds.
In the 1990s, Japanese scientists (Dr. Teruo Higa) began to differentiate the various hierarchical functions and levels of microorganisms and to select those microorganisms that are able to make a targeted contribution to the harmonisation and productivity of the processes in their environment.
We call them the CEOs and designers of production processes. Clinics like the Shokokai Clinic (EM Clinic) in Japan observed Inflammation caused by chronic rheumatism disappear and there have been improvements not just in cases of cancer, but in Parkinson’s, ALS, and dementia.
14 Years of Research at Chan Ka Vergel
Dr. Teruo Higa
In a 14-year research process at Chan Ká Vergel, we succeeded in isolating and reproducing them in such a way that we can now use them under any conditions to promote health and productivity.
The composition of these microorganisms cannot be clearly identified in the laboratory because the different species they contain are not always active or visible and we do not know the different resting stages of the microorganisms.
Even the best scientific microscopes have not yet been able to identify them.
But even if we could identify them, there is certainly no expert who could clearly classify them on the basis of optical characteristics.
